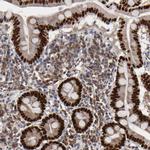
HNF4A Antibody in Immunohistochemistry (Paraffin) (IHC (P))

Search
Invitrogen
HNF4A Polyclonal Antibody
{{$productOrderCtrl.translations['antibody.pdp.commerceCard.promotion.promotions']}}
{{$productOrderCtrl.translations['antibody.pdp.commerceCard.promotion.viewpromo']}}
{{$productOrderCtrl.translations['antibody.pdp.commerceCard.promotion.promocode']}}: {{promo.promoCode}} {{promo.promoTitle}} {{promo.promoDescription}}. {{$productOrderCtrl.translations['antibody.pdp.commerceCard.promotion.learnmore']}}
产品信息
PA5-82159
种属反应
已发表种属
宿主/亚型
分类
类型
抗原
偶联物
形式
浓度
规格
纯化类型
保存液
内含物
保存条件
运输条件
RRID
产品详细信息
Immunogen sequence: LLQEMLLGGS PSDAPHAHHP LHPHLMQEHM GTNVIVANTM PTHLSNGQMC EWPRPRGQAA TPETPQPSPP GGSGSEPYKL LPGAVATIVK PLSAIPQPTI TKQEV
Highest antigen sequence indentity to the following orthologs: Mouse - 91%, Rat - 92%.
靶标信息
Hepatocyte nuclear factor 4 alpha (HNF4 alpha) is an orphan nuclear receptor. HNF4a is expressed in the liver, kidney, intestine, and pancreas. Mutation of HNF4a in humans has been associated with maturity-onset diabetes of the young type 1 (MODY1). HNF4 binds to DNA as an exclusive homodimer. The HNF4a gene is alternatively spliced and may generate up to nine different isoforms, HNF4a1 through HNF4a9.
仅用于科研。不用于诊断过程。未经明确授权不得转售。
生物信息学
蛋白别名: FLJ39654; hepatic nuclear factor 4 alpha; Hepatocyte nuclear factor 4-alpha; HNF-4-alpha; HNF4-alpha; HNF4A wild type; HNF4a7; HNF4a8; HNF4a9; HNF4alpha10/11/12; Nuclear receptor subfamily 2 group A member 1; TCF-14; transcription factor; Transcription factor 14; Transcription factor HNF-4
基因别名: FRTS4; HNF4; HNF4A; HNF4a7; HNF4a8; HNF4a9; HNF4alpha; MODY; MODY1; NR2A1; NR2A21; TCF; TCF-14; TCF14
UniProt ID: (Human) P41235
Entrez Gene ID: (Human) 3172